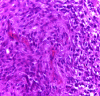

[Primary cerebral gliosarcoma: about two cases and review of the literature]
- PMID: 28904651
- PMCID: PMC5534136
- DOI: 10.11604/pamj.2017.27.14.8977
[Primary cerebral gliosarcoma: about two cases and review of the literature]
Abstract
Gliosarcoma is a very rare brain tumor accounting for 1.8 -8% of all glial tumors. It has been classified by the World Health Organization as a variant of glioblastoma. It is a tumor with double glial and sarcomatous component. Patient's clinical picture is polymorphic, imaging data are evocative, diagnosis is based on histology. Treatment is always surgical. Prognosis is closely linked to the quality of resection. We here report two clinical cases with the aim of assessing the diagnostic, therapeutic and prognostic features of this rare entity.
Le gliosarcome est une tumeur cérébrale très rare représentant 1,8 à 8% de l’ensemble des tumeurs gliales. Il est considéré par l’organisation mondiale de la santé comme une variante de glioblastome. C’est une tumeur à double composante gliale et sarcomateuse. Le tableau clinique est polymorphe, les données de l’imagerie sont évocatrices, la confirmation est histologique. Le traitement est essentiellement chirurgical. Le pronostic est lié étroitement à la qualité d’exérèse. Dans notre travail Nous rapportons deux observations cliniques dont l’objectif est de faire le point sur les particularités, essentiellement diagnostiques, thérapeutiques ainsi que pronostiques de cette entité rare.
Keywords: Primary gliosarcome; central nervous system; diagnosis; treatment.
Figures

References
-
- Woo SY. The brain and spinal cord. In: Cox JD, Ang K, editors. Radiation oncology. Rationale, technique, results. Philadelphia, PA: Mosby Elsevier; 2010. pp. 835–71.
-
- Malone JC, Brown KZ, Parker JC., Jr Pathologic quiz case. Gliosarcoma containing malignant fibrohistiocytic, osseous, and chondroid elements. Arch Pathol Lab Med. 1999 Apr;123(4):358–60. - PubMed
-
- Sreenan JJ, Prayson RA. Gliosarcoma. A study of 13 tumors, including p53 and CD34 immunohistochemistry. Arch Pathol Lab Med. 1997 Feb;121(2):129–33. - PubMed
-
- Perry JR, Ang LC, Bilbao JM, Muller PJ. Clinico pathologic features of primary and post irradiation cerebral gliosarcoma. Cancer. 1995 Jun 15;75(12):2910–8. - PubMed
Publication types
MeSH terms
LinkOut - more resources
Full Text Sources
Other Literature Sources
Medical
